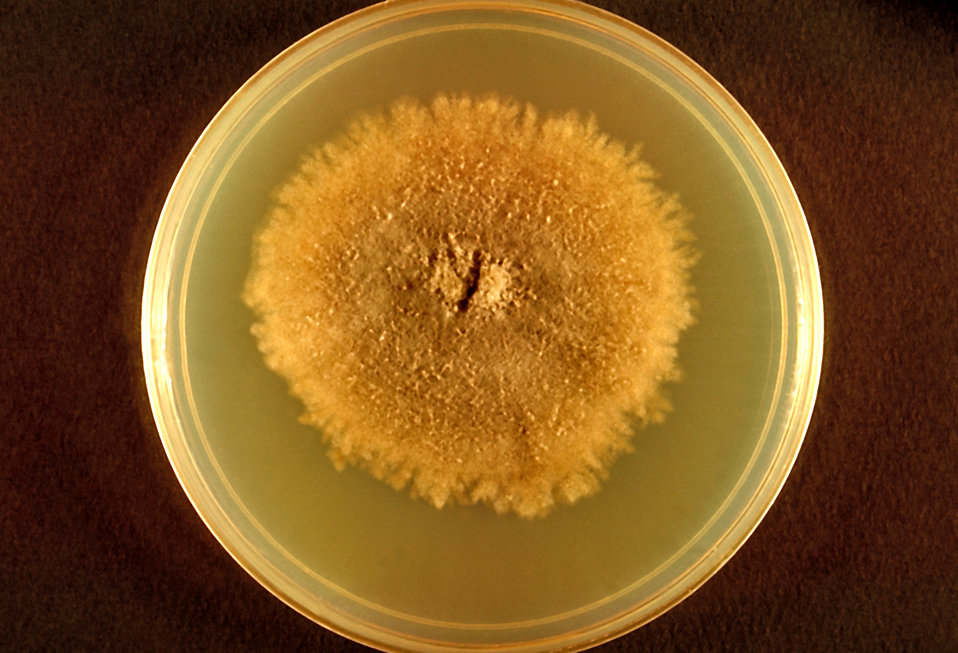
Public Domain Picture This Image Depicts A Plate Culture Containing A public-domain-picture-this-image-depicts-a-plate-culture-containing-a

Largest Fungal Colony are the ideal solution for remaining organized and managing your time effectively. These calendars come in a variety of formats, including monthly, weekly, and yearly designs, enabling you to choose the one that fits your planning style. Whether you're tracking consultations, setting goals, or handling your family's schedule, a printable calendar is a simple yet powerful tool. With customizable styles varying from minimalistic to vibrant styles, there's a choice to suit everyone's taste.
Downloading and printing a calendar is quick and hassle-free. You can print them in your home, work, or a regional store, making them available anytime you need them. Lots of templates even consist of pre-marked vacations and unique celebrations, saving you time. Start planning your days with a Largest Fungal Colony and delight in the benefits of a more organized and efficient life!
Largest Fungal Colony

Largest Fungal Colony
This two month calendar comes in a printable PDF format and it s free to download Paper size US Letter Document dimensions 8 5 by 11 inches This June, July and August 2025 calendar is great for planning your vacation during the school summer break. The printable 3 month calendar is available as ...
July 2025 Printable Calendar

Unveiling The World s Largest Fungal Colony A Hidden Giant Beneath The
Largest Fungal ColonyJune 2025 Calendar with Holidays and Celebrations of the United States. June 2025 has 20 work days. United States July 2025 Calendar with American holidays Monthly calendar for the month July in year 2025 Calendars online and print friendly for any
July 2025 Calendar with Holidays in printable format - United States. Includes 2025 Observances, Fun Facts & Religious Holidays: Christian, Catholic, ... Olympic Peninsula Fungi Festival A Fungal Colony Of The Fusarium Solani Growing On Pda B
June July August 2025 Calendar

Colonies Of Different Bacteria And Mold Fungi Grown On Petri Dish With
Free July 2025 month calendar templates in PDF Word and Excel that are printable downloadable fillable and editable Public Domain Picture This Photograph Depicts The Frontal View Of A
Calendars online and print friendly for any year and month and including public holidays and observances for countries worldwide Public Domain Picture This Photomicrograph Revealed Some Of The Public Domain Picture This Photomicrograph Revealed Some Of The

Fungal Colony Sim 2 By SkylorBeck

Public Domain Picture This Image Depicts A Reverse View I e View
Public Domain Picture This Image Depicts A Plate Culture Containing A

Public Domain Picture This Is A Front View Of A Petri Dish Culture

Public Domain Picture This Is A Front View Of A Petri Dish Culture

Public Domain Picture Photographed From The Front This 1971 Image

Public Domain Picture This Is A Top View Of A Sabouraud s Dextrose

Public Domain Picture This Photograph Depicts The Frontal View Of A

The Complete List Of Grassland Decomposers Flora Fauna Fun

SCIplanet Oregon s Giant The Largest Organism On Earth